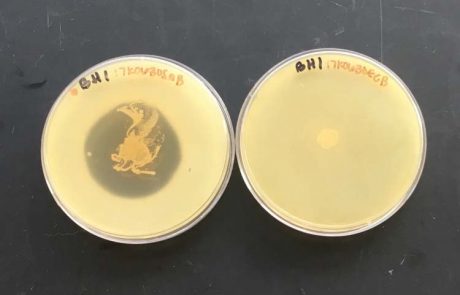

Dr. Jason Baker, Professor
(816) 271-4380 | jcbaker@missouriwestern.edu
Dr. Baker has been at MWSU since 2000. His research interests include protein biochemistry, Bacteriocin discovery and characterization, Science education and literacy, and industrial and applied microbiology.
Discovery and Characterization of New Antimicrobial Compounds
With the rise in drug resistant microorganisms causing ever more severe disease in humans, livestock, and companion animals the discovery of new antimicrobial compounds remains a scientific and medical focus. The soil contains thousands of uncharacterized species and strains of bacteria and fungi, many of which make compounds to defend themselves. These soil microbes have generated dozens of currently-used antibiotics and remain one of the best sources of potential new antimicrobial compounds, either antibiotics or bacteriocins. In this project we sample a large diversity of soil environments and isolate microorganisms which can be cultures in the lab. We survey those isolates for antimicrobial effects. Species with promising effects can be identified and the antimicrobial effects characterized. Any discovery could be the lead necessary to develop the next effective antimicrobial drug.
Requirements: Preference given to students with previous microbiology experience.
Analysis of Survey Data:
College Classes during COVID-19
Requirements – Attention to detail, experience with Excel, graphing, and statistics. Interest in data analysis/management.

About Dr. Jason Baker
Ph.D., Biochemistry, Kansas State University
B.S., Biochemistry, Kansas State University
Contact Dr. Baker
Agenstein 237D